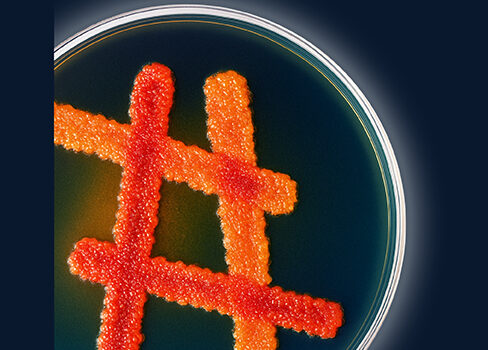
qui-sommes-nous-alliance-bio-expertise

Une entreprise
Découvrez nos engagements
Chez Alliance Bio Expertise, nous concevons, fabriquons et distribuons des solutions innovantes pour les laboratoires de microbiologie, de biologie et la Recherche.
Notre engagement : associer savoir-faire technique, accompagnement terrain et qualité pour répondre aux exigences des laboratoires en France et dans le monde entier.
Découvrez notre histoire, nos valeurs, nos engagements et rejoignez une équipe passionnée au service de la microbiologie.